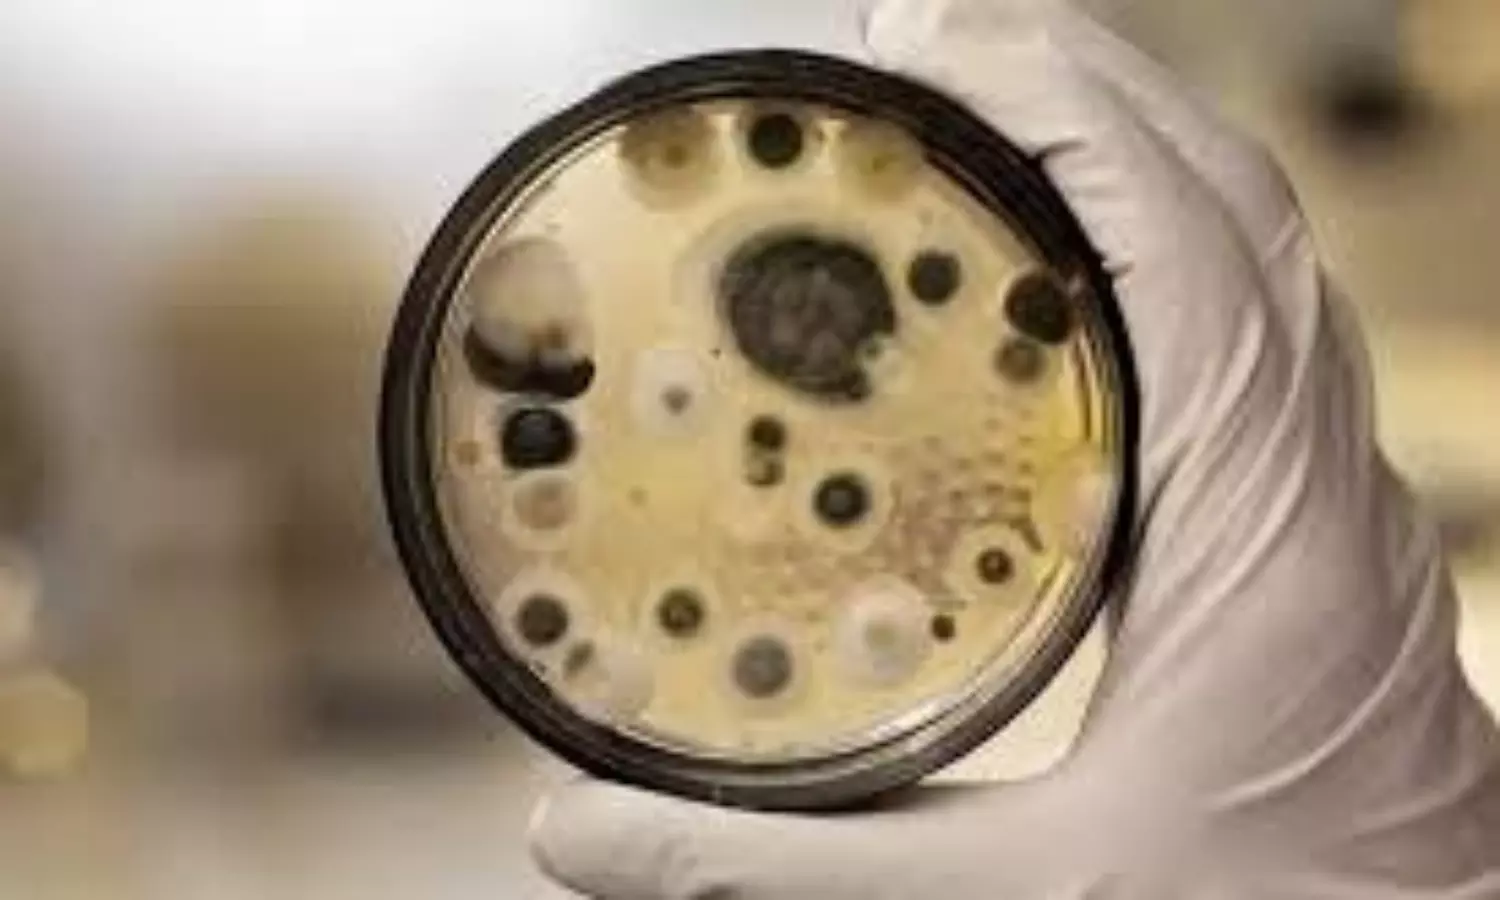
pharaoh’s curse fungus

ARCHIVE SiteMap 2025-06-23
 "Keep oil prices down. I am watching": Trump issues strong warning amid Middle East unrest
"Keep oil prices down. I am watching": Trump issues strong warning amid Middle East unrest Qatar: Explosions heard in Doha as Iran missiles US bases
Qatar: Explosions heard in Doha as Iran missiles US bases Pharaoh's curse fungus may hold key to fighting cancer: Penn scientists
Pharaoh's curse fungus may hold key to fighting cancer: Penn scientists Sharjah Expo Centre super sale returns with big deals from June 26
Sharjah Expo Centre super sale returns with big deals from June 26 Honeymoon murder cases fuel surge in private investigations of brides in Madhya Pradesh
Honeymoon murder cases fuel surge in private investigations of brides in Madhya Pradesh School principal arrested for fatally beating daughter over low NEET mock test score
School principal arrested for fatally beating daughter over low NEET mock test score Hyundai’s cold bed engine testing prevents over 2 million Kg of CO2 emissions, saves $1 million
Hyundai’s cold bed engine testing prevents over 2 million Kg of CO2 emissions, saves $1 million Amazon Diagnostics debuts in India, bringing at-home lab test services to six cities
Amazon Diagnostics debuts in India, bringing at-home lab test services to six cities V.S. Achuthanandan hospitalised after cardiac arrest; condition stable
V.S. Achuthanandan hospitalised after cardiac arrest; condition stable Tripura declared India’s 3rd fully literate state
Tripura declared India’s 3rd fully literate state Apple reportedly weighing acquisition of Perplexity AI in strategic push for AI development
Apple reportedly weighing acquisition of Perplexity AI in strategic push for AI development Massive Israeli strikes hit Tehran, smoke engulfs city skyline
Massive Israeli strikes hit Tehran, smoke engulfs city skyline